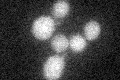
YIL041W
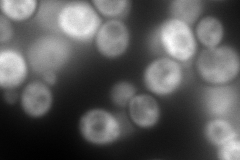
YIL041W
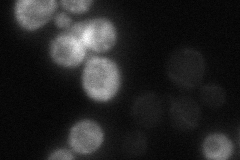
YIL041W
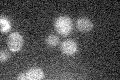
YIL041W

View description
BAR domain-containing protein that localizes to both early and late Golgi vesicles; required for adaptation to varying nutrient concentrations, fluid-phase endocytosis, polarization of the actin cytoskeleton, and vacuole biogenesis
Localization:
Intensity:
Fold change:
Significance:
-
C’ GFP library in SD
below threshold15.47 -
N' NOP1pr-GFP in SD

cytosol295.106 -
N' TEF2pr-mCherry in SD
cytosol395.302 -
N' NATIVEpr-GFP in SD
cytosol,punctate20.6099 -
N' TEF2pr-VC and Cyto-VN in SD

ER,punctate68.1469 -
C’ GFP library in SD+DTT

cytosol17.241.11No -
C’ GFP library in SD+H2O2

cytosol17.831.15No -
C’ GFP library in Starvation Media
cytosol15.230.98No -
C’ GFP library on the background of Pup2-DaMP

below threshold -
C’ GFP library on the background of CCT mutant

below threshold17.01241.09932No
